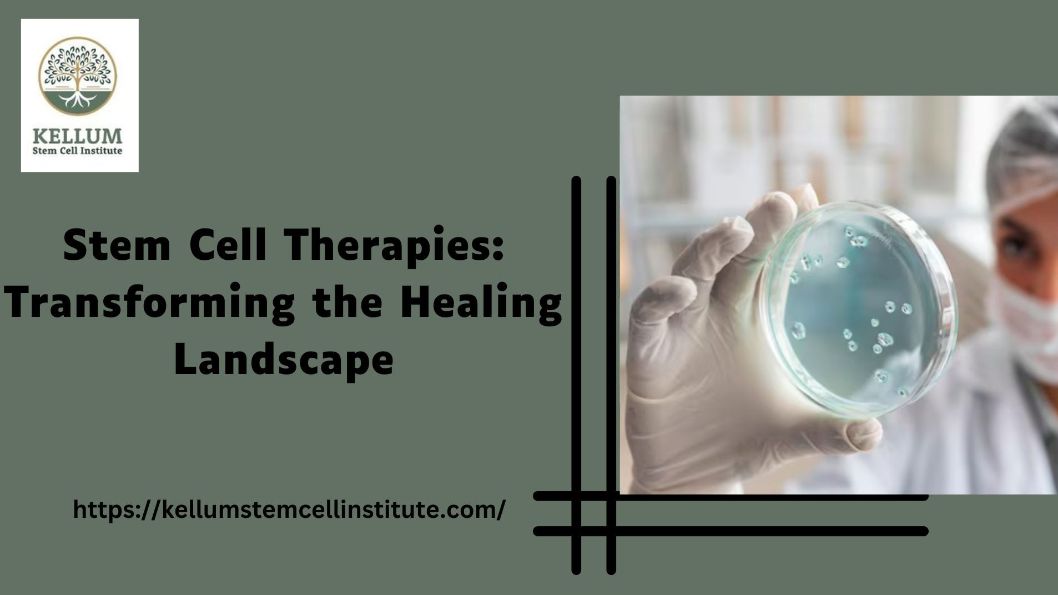

MaxLearn_ The Ultimate Microlearning Platform for Modern Training Needs
Business
17 Views
6 months ago
pdf
Conversational AI for Personalized Lead Nurturing
Technology
19 Views
6 months ago
pptx
Catering Success: How to Impress at Corporate Conferences
Food & Cooking
8 Views
6 months ago
ppt
Key Metrics to Include in Sustainability Reporting in France
Business
17 Views
6 months ago
pdf
Stem Cell Therapies: Transforming the Healing Landscape
Health & Medicine
19 Views
6 months ago
pptx
ADVANCED SERVER COOLING INNOVATIVE RACKS FOR HIGH-PERFORMANCE DATA CENTERS
Business
12 Views
6 months ago
pdf